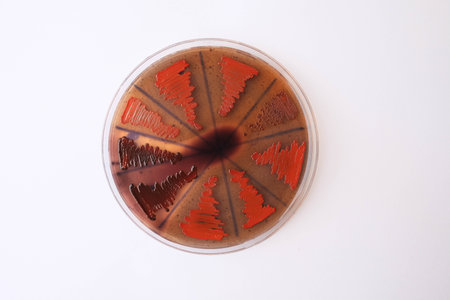
closeup photo of bacterilal colonies grown on agar mediaの写真素材

写真素材 - closeup photo of bacterilal colonies grown on agar media
キーワード
- agar
- aureus
- bacteria
- bacterial
- bacteriology
- biofilm
- biofilm production
- biological
- biology
- biotechnology
- black colony
- blood
- colonies
- colony
- congo red agar
- culture
- diagnostics
- disease
- dish
- experiment
- gram
- growth
- health
- inspection
- iraq
- lab
- laboratory
- media
- medical
- microbe
- microbiology
- microorganism
- morphology
- pathogen
- petri
- pick up
- pigment
- plate
- produce
- red agar
- research
- science
- scientific
- single colony
- slime
- staphylococcus
- streak
- streak plate
- test
- top view
類似作品
Explore the uns...
close-up of vib...
Backgrounds of ...
Backgrounds of ...
Air bubbles ins...
Close up petri ...
Microscopic vie...
Close-up of a c...
Backgrounds of ...
A petri dish te...
Mold Beautiful,...
Various types o...
Backgrounds of ...
Backgrounds of ...
Texture of natu...
Backgrounds of ...
Backgrounds of ...
Yeast in petri ...
Backgrounds of ...
An artistic dis...
A detailed view...
close-up of bac...
Mold Beautiful,...
Backgrounds of ...
Staphylococcus ...
Backgrounds of ...
Escherichia col...
A petri dish te...
This vivid view...
some pearls wit...
Backgrounds of ...
Backgrounds of ...
Backgrounds of ...
iron textures
Close up petri ...
Backgrounds of ...
Close up petri ...
Ink liquid. Pai...
Backgrounds of ...
A close-up of a...
Petri dish clos...
In the microsco...
Glowing colonie...
Laboratory grow...
Backgrounds of ...
Petri plate wit...
Colorful variet...
Colony characte...
Characteristics...